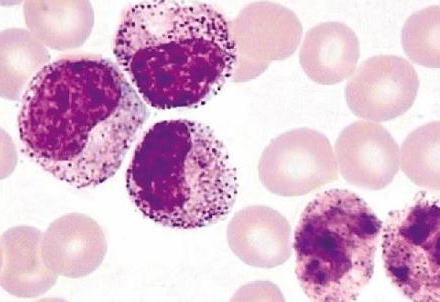

【资讯导读】靶向药物在临床肿瘤治疗中的疗效明显优于传统治疗,且毒副作用也明显降低。第一代Bcr/Abl酪氨酸激酶抑制剂甲磺酸伊马替尼,商品名格列卫。其作用机制是抑制酪氨酸激酶磷酸化,
靶向药物在临床肿瘤治疗中的疗效明显优于传统治疗,且毒副作用也明显降低。第一代Bcr/Abl酪氨酸激酶抑制剂甲磺酸伊马替尼,商品名格列卫。其作用机制是抑制酪氨酸激酶磷酸化,防止其精细增殖和肿瘤形成,并选择性抑制酪氨酸激酶下游信号转导途径,如血小板衍生生长因子(PDGF)。

、
适应症:伊马替尼主要用于治疗髓系白血病;胃肠道间质瘤和小细胞肺癌的治疗。伊马替尼的主要不良反应是皮疹、水肿和胃肠道反应。对于服用伊马替尼的患者,应注意以下几点:1)应在进餐时服用伊马替尼,并应饮用一大杯水。2)一般来说,成人每天服用400毫克或600毫克。如果每日剂量为800毫克,则每天应服用两次400毫克(早上和晚上)。
3)对于不能吞服胶囊的患者(老人或儿童),可将胶囊中的药物分散在水中或苹果汁中服用(100毫克片剂50毫升,400毫克片剂200毫升)。片剂完全崩解后,应立即搅拌并服用混悬液。4)建议怀孕和哺乳期间的妇女在打开胶囊时避免接触皮肤或眼睛或吸入伊马替尼。触摸并打开胶囊后立即洗手。
伊马替尼药品详细信息请进入:https://www.inmedf.com/zhongliu/bxb/201950.html
、
、